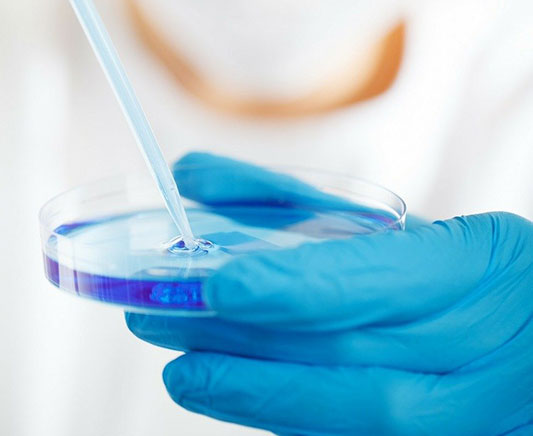

服务热线:
13318807425

广州赟创医药科技有限公司成立于2013年09月,位于广州市番禺万博、南站商务圈,交通十分便利;公司作为专业的器械、耗材销售公司,打造成为医疗器械行业内具有良好品牌和专业学术推广的公司。本公司是一家专业从事医疗器械、特医食品等销售企业,经营范围涵盖医疗器械Ⅰ、Ⅱ、Ⅲ类。
公司崇尚“亿兆壹心,康泽众生”的企业精神,在广东及全国业务拓展多年,积累了多年行业经验,在业内建立了非常好的口碑;公司本着“团结、紧张、互助、共赢”的管理理念,打造了一支敬业务实,实战力强的高素质专业销售队伍。
广州赟创医药科技有限公司诚邀您的加入,公司将为您提供理想与飞跃的发展平台
地址:广州市番禺区大石街御峰二街55号2栋828
服务热线:13318807425
Copyright 广州赟创医药科技有限公司粤ICP备2021054083号